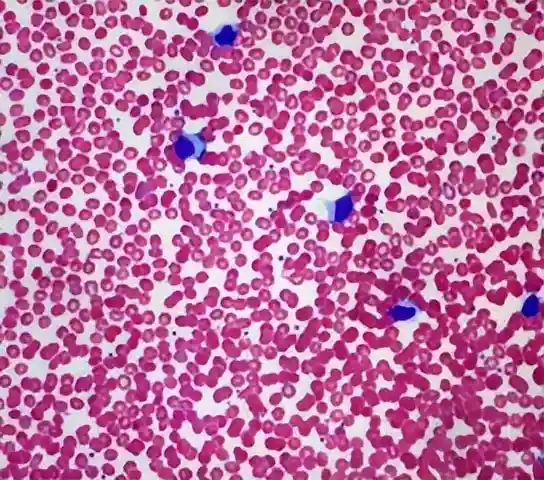
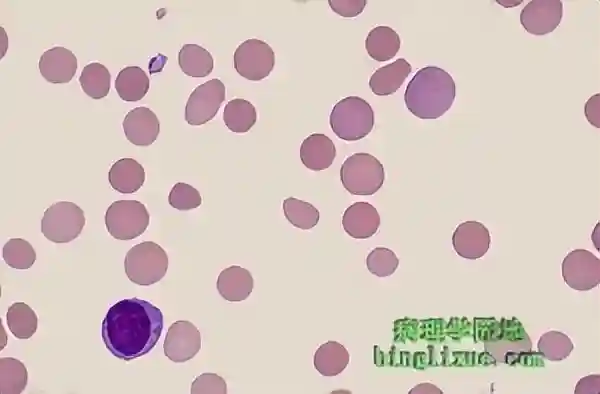

细胞增多症(Polycythemia,PCV)是指单位体积的外周血中红细胞计数、血红蛋白浓度及血细胞比容(HCT)高于正常范围。它可以是相对性的(因血浆容量减少,使红细胞相对增多),也可以是绝对性的(红细胞数量真正增多)。绝对性红细胞增多症又分为原发性和继发性。
一、病因及发病机制
1.相对性红细胞增多症
病因:主要是由于血液浓缩导致。常见于严重呕吐、腹泻、大面积烧伤等导致体液大量丢失,以及使用利尿剂等情况,使血浆容量减少,而红细胞数量相对增多。
发病机制:当机体出现脱水情况时,血浆中的水分丢失,血液中的细胞成分相对浓缩。例如,在严重腹泻时,大量的肠液丢失,其中含有较多的水分和电解质,使得血管内的血浆容量快速下降,而红细胞数量在短时间内没有改变,从而导致红细胞计数、血红蛋白浓度和血细胞比容等升高。

2.绝对性红细胞增多症-原发性(真性红细胞增多症)
病因:是一种造血干细胞的克隆性疾病,主要由JAK2-V617F等基因突变引起。这种突变使得红细胞生成素(EPO)非依赖性红细胞增殖,导致红细胞过度产生。
发病机制:JAK2-V617F突变导致JAK-STAT信号通路异常激活,细胞内信号传导紊乱。在骨髓中,造血干细胞在这种异常信号的刺激下,不受正常调节机制的控制,不断增殖并分化为大量红细胞。同时,还可能伴有白细胞和血小板的增多,因为突变影响的是造血干细胞,也会导致其他血细胞系列的异常增殖。
3.绝对性红细胞增多症-继发性
病因:是由于机体长期缺氧或EPO分泌增多等原因引起。常见于慢性阻塞性肺疾病(COPD)、先天性心脏病(右向左分流型)等导致长期缺氧的疾病,以及肾囊肿、肾肿瘤等使EPO分泌增加的情况。
发病机制:在慢性缺氧状态下,机体为了代偿缺氧,通过肾脏等器官的缺氧感应机制,促使EPO分泌增加。EPO作用于骨髓中的红系祖细胞,刺激其增殖和分化,从而使红细胞生成增多。在肾囊肿或肾肿瘤等情况下,异常的肾脏组织可能会自主性地分泌过多EPO,导致红细胞生成增多。

二、临床表现
1.皮肤和黏膜改变:患者的皮肤和黏膜呈现红润色泽,尤其是面部、口唇、鼻尖、耳垂等部位,颜色明显发红,类似醉酒面容。这是因为红细胞增多导致血液颜色加深,透过皮肤和黏膜表现出来。
2.神经系统症状:患者可能出现头痛、头晕、耳鸣、视力模糊、记忆力减退等症状。这是由于血液黏稠度增加,血流缓慢,导致脑部供血不足和血管扩张。例如,当血液黏稠度升高时,血液在脑血管内的流动阻力增大,脑血流量减少,引起脑组织缺氧,从而出现头痛、头晕等症状。

3.循环系统症状:可出现心慌、心悸、血压升高。因为红细胞增多使血容量增加,心脏需要更大的力量来推动血液循环,导致心脏负担加重,同时血管内压力也会升高。长期的心脏负荷增加还可能导致心肌肥厚。
4.消化系统症状:部分患者可能有消化性溃疡、脾肿大等表现。脾肿大是因为脾脏参与血细胞的清除和储存,红细胞增多时脾脏的工作负荷增大,导致脾脏代偿性增大。消化性溃疡的发生可能与血液黏稠度增加,胃肠道黏膜微循环障碍有关。
5.出血倾向:患者可能出现鼻出血、牙龈出血、皮肤瘀斑等出血症状。这是由于血液黏稠度增加,血流缓慢,导致血小板的功能受到影响,同时血管内皮也可能因为血液动力学的改变而受损,增加了出血的风险。

三、实验室诊断
1.血常规检查:红细胞计数男性6.0×10¹²/L、女性5.5×10¹²/L,血红蛋白浓度男性170g/L、女性160g/L,血细胞比容男性0.54、女性0.50,是红细胞增多症的主要诊断指标。同时还可以观察到白细胞和血小板计数可能也会升高,特别是在真性红细胞增多症中。
2.骨髓检查:骨髓穿刺涂片显示骨髓增生明显活跃,以红系增生为主,粒系和巨核系也可能增生。在真性红细胞增多症中,还可以通过基因检测发现JAK2-V617F等相关基因突变,这对于确诊原发性红细胞增多症非常重要。

3.血液流变学检查:可以检测血液黏稠度,红细胞增多症患者血液黏稠度明显升高。这有助于了解血液的流动性和黏稠状态,对于评估病情和指导治疗有重要意义。
4.其他检查:对于继发性红细胞增多症,还需要进行相关检查寻找病因。例如,检查动脉血氧饱和度,如果患者有慢性缺氧疾病,动脉血氧饱和度可能会降低;检查肾功能和肾脏超声等,以发现是否存在肾囊肿或肾肿瘤等导致EPO分泌增加的情况。
四、影像学检查
1.超声检查:可以用于检查脾脏大小,判断是否有脾肿大。在红细胞增多症患者中,脾脏可能会出现轻、中度肿大,超声下可观察到脾脏的长径、厚度等指标超过正常范围。同时,超声还可以对肾脏进行初步检查,观察肾脏的形态、大小等,为寻找继发性红细胞增多症的病因提供线索。
2.CT和MRI检查:CT检查在发现潜在的引起继发性红细胞增多症的肾脏病变(如肾肿瘤)方面更敏感。MRI对于观察骨髓的情况有一定优势,例如在真性红细胞增多症中,MRI可以显示骨髓信号的改变,反映骨髓的增生状态。

五、临床管理
1.一般治疗:对于相对性红细胞增多症,主要是补充液体,纠正脱水状态。如对于严重腹泻导致的血液浓缩,及时补充生理盐水、葡萄糖溶液等,以恢复正常的血浆容量,随着体液平衡的恢复,红细胞计数等指标会逐渐恢复正常。
2.针对病因治疗-继发性红细胞增多症:如果是慢性缺氧疾病引起的,如COPD,应积极治疗原发病,改善通气功能,如使用支气管扩张剂(沙丁胺醇等)、氧疗等措施,减轻机体缺氧状态,从而减少EPO的分泌,使红细胞生成逐渐恢复正常。对于肾肿瘤等引起的,可能需要进行手术切除肿瘤等治疗。
3.药物治疗-原发性红细胞增多症(真性红细胞增多症):
(1)羟基脲:是一种常用的化疗药物,它可以抑制骨髓细胞的增殖,降低红细胞数量。通过干扰DNA合成,阻止造血干细胞过度增殖,从而控制红细胞增多。但使用过程中需要注意监测血常规,避免过度抑制骨髓造血。
(2)干扰素-α:具有调节免疫和抗增殖的作用,用于治疗真性红细胞增多症。它可以抑制JAK-STAT信号通路,减少红细胞的生成。其副作用可能包括发热、乏力、肌肉酸痛等流感样症状。
4.放血治疗:是治疗红细胞增多症的一种有效方法,特别是对于真性红细胞增多症和血细胞比容过高的患者。通过定期放血,可以迅速降低血细胞比容,减轻血液黏稠度,改善症状。一般每次放血300-500ml,根据患者的情况可以每周1-2次。放血治疗过程中要注意监测血常规,防止过度放血导致贫血。同时,放血后可适当补充铁剂,因为频繁放血可能导致铁丢失。